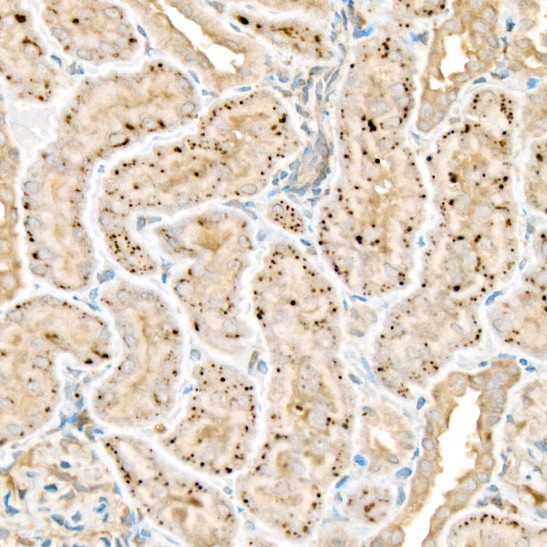
WNT2 Antibody in Immunohistochemistry (Paraffin) (IHC (P))

Search
Invitrogen
WNT2 Polyclonal Antibody
{{$productOrderCtrl.translations['antibody.pdp.commerceCard.promotion.promotions']}}
{{$productOrderCtrl.translations['antibody.pdp.commerceCard.promotion.viewpromo']}}
{{$productOrderCtrl.translations['antibody.pdp.commerceCard.promotion.promocode']}}: {{promo.promoCode}} {{promo.promoTitle}} {{promo.promoDescription}}. {{$productOrderCtrl.translations['antibody.pdp.commerceCard.promotion.learnmore']}}
图: 1 / 2
WNT2 Antibody (PA5-96453) in IHC (P)


Please note: We are reviewing Western blot images included in the antibody testing data in our catalog, including those provided by third parties. Unless expressly labeled or annotated as “raw-unedited”, Western blot images included in the antibody testing data in our catalog may have been edited, optimized or otherwise adjusted for presentation.
产品信息
PA5-96453
种属反应
宿主/亚型
分类
类型
抗原
偶联物
形式
浓度
规格
纯化类型
保存液
内含物
保存条件
运输条件
RRID
产品详细信息
Immunogen sequence: SWWYMRATGG SSRVMCDNVP GLVSSQRQLC HRHPDVMRAI SQGVAEWTAE CQHQFRQHRW NCNTLDRDHS LFGRVLLRSS RESAFVYAIS SAGVVFAITR ACSQGEVKSC SCDPKKMGSA KDSKGIFDWG GCSDNIDYGI KFARAFVDAK ERKGKDARAL MNLHNNRAGR KAVKRFLKQE CKCHGVSGSC TLRTCWLAMA DFRKTGDYLW RKYNGAIQVV MNQDGTGFTV ANERFKKPTK NDLVYFENSP DYCIRDREAG SLGTAGRVCN LTSRGMDSCE VMCCGRGYDT SHVTRMTKCG CKFHWCCAVR CQDCLEALDV HTCKAPKNAD WTTAT; Positive Samples: SKOV3; Cellular Location: extracellular matrix, extracellular space
靶标信息
WNT2 is a ligand for members of the frizzled family of seven transmembrane receptors. Probable developmental protein. May be a signaling molecule which affects the development of discrete regions of tissues. Is likely to signal over only few cell diameters.
仅用于科研。不用于诊断过程。未经明确授权不得转售。
篇参考文献 (0)
生物信息学
蛋白别名: epididymis secretory sperm binding protein; Int-1-like protein 1; Int-1-related protein; INT1L 1; IRP; IRP protein; Protein Wnt-2; secreted growth factor; unnamed protein product; wingless-related MMTV integration site 2; wingless-type MMTV integration site 2; wingless-type MMTV integration site family member 2; WNT 2
基因别名: INT1L1; IRP; Wnt; WNT2
Entrez Gene ID: (Human) 7472, (Rat) 114487